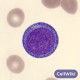
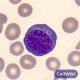
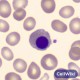
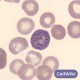
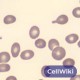

: Proeritoblasto
: Proeritoblasto
: Eritroblasto basófilo
: Eritroblasto basófilo
: Eritroblasto ortocromático
: Eritroblasto ortocromático
: Punteado basofilo
: Punteado basofilo
 : Esquistocito
: Esquistocito
 : Equinocito
: Equinocito
 : Howell jolly
: Howell jolly
 : Anillo de cabot
: Anillo de cabot
 : Celulas diana
: Celulas diana
: Dacriocito
: Dacriocito
Otros juegos similares:
Otros juegos similares:
Otros juegos similares:























